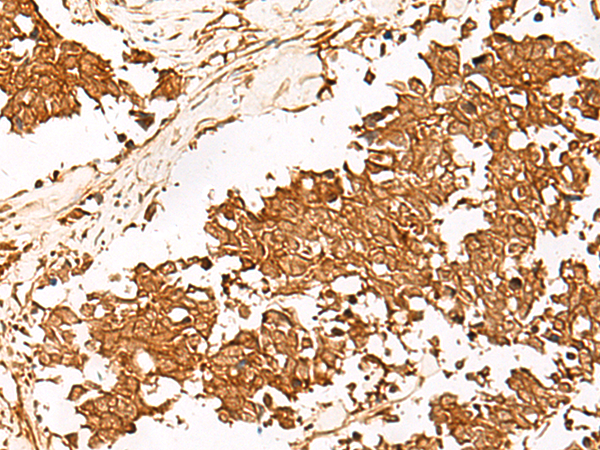

抗 原: HUS1
技術(shù)規(guī)格
|
Background: |
The protein encoded by this gene is a component of an evolutionarily conserved, genotoxin-activated checkpoint complex that is involved in the cell cycle arrest in response to DNA damage. This protein forms a heterotrimeric complex with checkpoint proteins RAD9 and RAD1. In response to DNA damage, the trimeric complex interacts with another protein complex consisting of checkpoint protein RAD17 and four small subunits of the replication factor C (RFC), which loads the combined complex onto the chromatin. The DNA damage induced chromatin binding has been shown to depend on the activation of the checkpoint kinase ATM, and is thought to be an early checkpoint signaling event. Alternative splicing results in multiple transcript variants. |
|
Applications: |
WB |
|
Name of antibody: |
HUS1 |
|
Immunogen: |
Fusion protein of human HUS1 |
|
Full name: |
HUS1 checkpoint clamp component |
|
Synonyms: |
hHUS1 |
|
SwissProt: |
O60921 |
|
WB Predicted band size: |
32 kDa |
|
WB Positive control: |
K562 cell |
|
WB Recommended dilution: |
200-1000 |

購(gòu)物車
購(gòu)物車 幫助
幫助
 021-54845833/15800441009
021-54845833/15800441009
